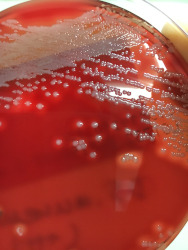

臨床検査とは
病気の原因を調べたり、治療の効果をみるために行われます。
臨床検査は、大きく2つに分類されます。
●検体検査・・・血液や尿・その他患者さんから採取した材料をもとに、その成分を調べる検査
●生理検査・・・患者さんの身体を直接調べる検査
常に迅速で正確なデータの提供を目指しており、一定時間内に報告し長時間お待たせすることの無いように心がけております。
臨床検査は、大きく2つに分類されます。
●検体検査・・・血液や尿・その他患者さんから採取した材料をもとに、その成分を調べる検査
●生理検査・・・患者さんの身体を直接調べる検査
常に迅速で正確なデータの提供を目指しており、一定時間内に報告し長時間お待たせすることの無いように心がけております。
業務内容の紹介
採血業務(外来)
 患者さんの血液を採取し分析します。分析結果は病気の診断に必要な情報として利用されます。診断が確定して治療が始まり、その効果を判定するためにも必要です。採血の際は、患者さんの氏名、生年月日等をお聞きしますが、ご本人の確認のために必要なことですのでご理解くださるようお願いします。また安全に配慮して採血しておりますが、ご気分が悪くなったりしたら遠慮なくお申し出ください。
患者さんの血液を採取し分析します。分析結果は病気の診断に必要な情報として利用されます。診断が確定して治療が始まり、その効果を判定するためにも必要です。採血の際は、患者さんの氏名、生年月日等をお聞きしますが、ご本人の確認のために必要なことですのでご理解くださるようお願いします。また安全に配慮して採血しておりますが、ご気分が悪くなったりしたら遠慮なくお申し出ください。検体検査 (生化学・免疫検査、血液・凝固検査など)
 ●生化学検査は患者さんから血液を採取し、肝臓の働き、腎臓の働きなどを調べます。
●生化学検査は患者さんから血液を採取し、肝臓の働き、腎臓の働きなどを調べます。肝機能・・・AST(GOT)、ALT(GPT)、γ-GTPなど
腎機能・・・BUN(血中尿素窒素)、クレアチニンなど
●免疫検査は甲状腺をはじめとしたホルモンの値や、腫瘍マーカー、肝炎ウイルスなどの感染症を調べます。
●血液検査は血液中の赤血球、白血球、血小板などを調べ、貧血の有無、血液細胞の異常などを見つけます。
貧血・・・赤血球数、ヘモグロビン濃度など
血液細胞の異常・・・顕微鏡による観察
●凝固検査は血の止まりにくさなどを調べる検査になります。
患者さんの血液を分析する際は、主に自動分析装置を用います。
日によって測定値が変動しないように、同じ値を示すコントロール物質を測定してから患者さんの血液を測定します。これを精度管理と言います。
私どもは分析のプロフェッショナルを目指し、日々努力いたします。
検体検査 (微生物検査)
 ●感染症を疑う患者さんの検体(喀痰、尿、便、血液など)から原因微生物を特定します。また治療に使用する抗菌薬の効きを調べたりします。
●感染症を疑う患者さんの検体(喀痰、尿、便、血液など)から原因微生物を特定します。また治療に使用する抗菌薬の効きを調べたりします。●院内感染を防ぐ感染管理業務にも参加しています。

検体検査 (尿一般検査)
 ●尿検体は負担がかからず採取しやすく、それでいて情報量の多い検査項目です。
●尿検体は負担がかからず採取しやすく、それでいて情報量の多い検査項目です。●尿試験紙で潜血、尿たんぱく、尿糖などを調べます。
●尿沈渣は尿中に出現する様々な成分(細胞、結晶、円柱など)を顕微鏡で調べます。

生理検査 (超音波検査など)
 ●依頼目的に応じて、腹部臓器、心臓、 頸動脈、甲状腺、乳腺、下肢静脈などを超音波診断装置で調べます。異常があればすぐに医師に伝えます。
●依頼目的に応じて、腹部臓器、心臓、 頸動脈、甲状腺、乳腺、下肢静脈などを超音波診断装置で調べます。異常があればすぐに医師に伝えます。●当院で行っている生理検査は超音波検査のほかに、心電図(安静時、エルゴメーター運動負荷、24時間ホルター心電図)、肺機能、血圧脈波、睡眠時無呼吸検査(簡易PSG、精密PSG)、聴力検査などがあります。
検査室スタッフ 令和7年4月1日現在
●臨床検査室長・・・医師1名
●臨床検査技師・・・11名
●看護師(採血)・・・1名
●業務補助員(受付)・・・2名
●臨床検査技師・・・11名
●看護師(採血)・・・1名
●業務補助員(受付)・・・2名
施設基準届出状況(検査室関連) 令和7年4月1日現在
●検体検査管理加算(Ⅰ)
●検体検査管理加算(Ⅱ)
●外来迅速検体検査加算
●輸血管理料(Ⅱ)
●感染対策向上加算1
●検体検査管理加算(Ⅱ)
●外来迅速検体検査加算
●輸血管理料(Ⅱ)
●感染対策向上加算1
認定資格(検査室関連) 令和7年4月1日現在
●超音波検査士(循環器領域):日本超音波医学会・・・1名
●JHRS認定心電図専門士:日本不整脈心電学会・・・1名
●乳がん検診超音波検査実施技師(日本乳がん検診精度管理中央機構)・・・1名
●緊急臨床検査士:日本臨床検査同学院・・・1名
●二級臨床検査士(免疫血清学):日本臨床検査同学院・・・1名
●宮城県肝炎医療コーディネーター・・・2名
●毒物劇物取扱者(一般)・・・1名
●JHRS認定心電図専門士:日本不整脈心電学会・・・1名
●乳がん検診超音波検査実施技師(日本乳がん検診精度管理中央機構)・・・1名
●緊急臨床検査士:日本臨床検査同学院・・・1名
●二級臨床検査士(免疫血清学):日本臨床検査同学院・・・1名
●宮城県肝炎医療コーディネーター・・・2名
●毒物劇物取扱者(一般)・・・1名
所属学会など(検査室関連) 令和7年4月1日現在
●日本臨床衛生検査技師会・・・11名
●日本臨床化学会・・・1名
●日本医療検査科学会(旧:日本臨床検査自動化学会)・・・1名
●日本臨床微生物学会・・・1名
●日本環境感染学会・・・1名
●日本超音波医学会・・・1名
●日本超音波検査学会・・・7名
●日本心エコー図学会・・・1名
●日本不整脈心電学会・・・1名
●日本臨床化学会・・・1名
●日本医療検査科学会(旧:日本臨床検査自動化学会)・・・1名
●日本臨床微生物学会・・・1名
●日本環境感染学会・・・1名
●日本超音波医学会・・・1名
●日本超音波検査学会・・・7名
●日本心エコー図学会・・・1名
●日本不整脈心電学会・・・1名
※画像の著作権は登米市医療局にあります。2次利用等はお控えください。




